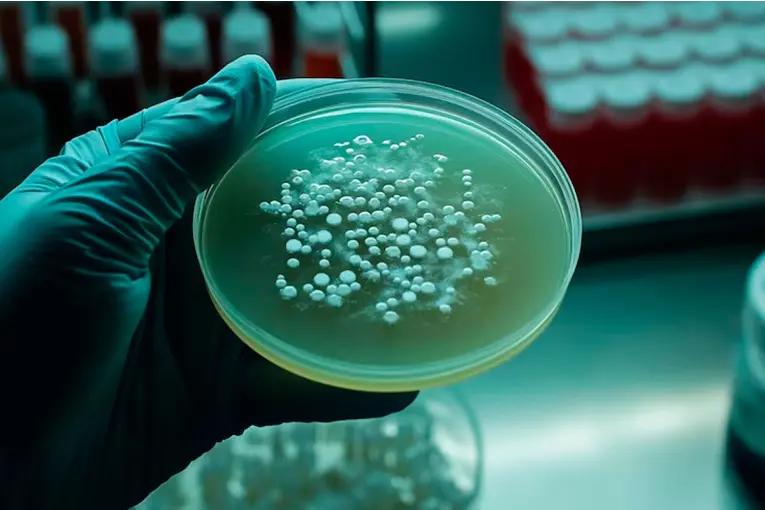
1

Investigadores del CONICET y la Universidad Nacional de Hurlingham demostraron que la combinación de un compuesto del cannabis y un antibiótico potencia el tratamiento contra bacterias multirresistentes, una de las mayores amenazas para la salud global.
Un equipo de científicos argentinos logró un avance significativo en la lucha contra las bacterias resistentes a los antibióticos, responsables de más de 700 mil muertes anuales en el mundo. El hallazgo fue realizado por investigadores del CONICET y la Universidad Nacional de Hurlingham (UNAHUR) y demuestra que la combinación del cannabidiol (CBD) —un compuesto no psicoactivo del cannabis— con un antibiótico de uso común permite eliminar bacterias gramnegativas multirresistentes.
El estudio fue publicado en la revista científica Pharmaceutics y abre una nueva posibilidad terapéutica frente a infecciones que hoy resultan extremadamente difíciles de tratar, sobre todo en ámbitos hospitalarios.
Un efecto sinérgico que potencia el tratamiento
Según explicó Paulo Maffía, director del Laboratorio de Aplicaciones Biotecnológicas y Microbiología (LABYM) de la UNAHUR, los ensayos de laboratorio demostraron que el CBD potencia el efecto de la colistina, un antibiótico considerado de “última línea” para combatir microorganismos resistentes.
“Con cannabidiol podemos disminuir las dosis de colistina necesarias para eliminar estas bacterias y, de ese modo, reducir los efectos secundarios”, señaló el investigador. Entre esas complicaciones se encuentran la nefrotoxicidad y la neurotoxicidad, que suelen limitar el uso de este antibiótico en pacientes críticos.
Las bacterias más peligrosas
La investigación se centró en bacterias gramnegativas multirresistentes, un grupo que incluye especies como Escherichia coli, Acinetobacter baumannii, Salmonella typhimurium y Klebsiella pneumoniae. Estos microorganismos suelen encontrarse en hospitales, especialmente en unidades de terapia intensiva, y pueden causar infecciones graves en pulmones, sangre, vías urinarias y heridas quirúrgicas.
Los científicos comprobaron que, si bien estas bacterias resisten tanto al CBD como a la colistina cuando se usan por separado, la combinación de ambos compuestos logra eliminarlas, incluso en su forma más compleja: los biofilms, estructuras que aumentan la resistencia bacteriana.
Un mecanismo de acción novedoso
El equipo utilizó técnicas avanzadas, como la resonancia magnética nuclear, para analizar el mecanismo molecular de la combinación. Los resultados evidenciaron una fuerte interacción entre el cannabidiol y la colistina, lo que permitió postular la existencia de un mecanismo antibacteriano inédito, capaz de vulnerar las defensas de estas “superbacterias”.
“Demostramos una marcada actividad antimicrobiana frente a cepas resistentes y una importante acción bactericida sobre los biofilms”, detalló Maffía.
Un aporte clave desde la ciencia argentina
El trabajo contó con la participación de investigadores del CONICET, la UNAHUR, el Instituto de Investigaciones Bioquímicas de Buenos Aires, la Fundación Instituto Leloir y el Instituto Malbrán. Para el rector de la UNAHUR, Jaime Perczyk, el descubrimiento “es un aporte importante para la salud y demuestra el rol de la universidad pública en la producción de conocimiento estratégico”, dio cuenta Infobae.
Si bien los resultados son prometedores, los especialistas aclararon que aún será necesario avanzar con ensayos preclínicos y clínicos para confirmar la seguridad y eficacia del tratamiento combinado antes de su aprobación.









